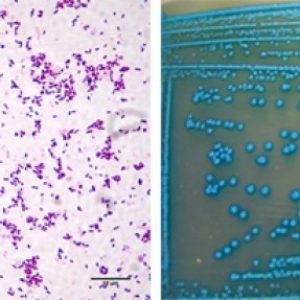

Практически все знают о том, что микробы и вирусы опасны для здоровья беременных и могут угрожать плоду развитием пороков или аномалий в период гестации. Особенно это опасно в первом и третьем триместре, что грозит крайне опасными фатальными последствиями. Но мало кто из будущих мам знает о такой инфекции как листериоз. А между тем эти микробы широко распространены во внешней среде, и очень опасны при беременности.
Важно
Внешне распознать эту инфекцию сложно, она при гестации очень похожа на банальные ОРВИ или на легкие кишечные расстройства, при этом угрожает запуском преждевременных родов, внутриутробной гибелью плода с мертворождением или в ранние сроки выкидышами.
Если заражение возникает практически перед родами, ребенок выживает, но имеет многочисленные проблемы со стороны внутренних органов и тканей, которые потребуют длительного наблюдения и лечения у специалиста, а также реанимационных мероприятий.
Общие данные о листериозе
Листериоз относится к числу микробных инфекций, которые опасны и очень актуальны в период гестации. Заражение может произойти через некоторые продукты питания, обсемененные листериями, возбудителями инфекции. Женщина в интересном положении, а также ее развивающийся плод, либо новорожденный ребенок, маленькие дети и взрослые с резко ослабленной иммунной системой особенно восприимчивы к листериям. Они способны приводить к сепсису, менингитам и различным инфекционным осложнениям, в том числе угрожающим жизни плода и затем уже и новорожденного.
Для самой женщины эта инфекция не так опасна, как для зародыша, плода или ребенка в родах, но встречается данное заболевание нечасто, около 2.5 тысяч случаев в год, и только треть из них – у будущих матерей.
Врачи подчеркивают, что листериоз представляет собой серьезную угрозу для беременных женщин и их будущих детей. Эта инфекция, часто называемая “болезнью холодильников”, вызывается бактерией Listeria monocytogenes, которая может находиться в неправильно хранящихся или недостаточно термически обработанных продуктах. Врачи отмечают, что заражение может привести к выкидышу, преждевременным родам или серьезным осложнениям у новорожденного, таким как менингит или сепсис. Особенно уязвимы женщины в первом и третьем триместре беременности. Специалисты рекомендуют беременным избегать употребления сыров с мягкой коркой, непастеризованных молочных продуктов и тщательно следить за сроками годности продуктов. Профилактика и осведомленность о рисках являются ключевыми факторами в защите здоровья матери и ребенка.

Особенности возбудителей
Листериоз в медицине стал известен не так давно, в то время как в ветеринарии его знают не первое столетие. Изначально бактерия поражала животных, как диких, так и домашних представителей, а люди болели редко, в основном те из них, кто тесно контактировал с животными на фермах, в клиниках, сельском хозяйстве. Обычно страдали люди, пренебрегающие личной гигиеной и имеющие снижение иммунитета в силу различных причин. Сегодня листериоз возникает у жителей городов и сел, которые встречаются с возбудителем – листерией. Микроб относится к одной группе с дифтерийным возбудителем, но имеет несколько отличные от нее свойства.
Особыми признаками для листерий является их выживание в неблагоприятных для других микробах условиях. Они могут активно выживать и даже размножаться в холодной воде и почве, в зараженных продуктах питания, которые хранятся в условиях холодильника.
Обратите внимание
Опасны также в отношении листерий вакуумные упаковки продуктов, их не убивает раствор соли до 20%, который применяют для засолки рыбы и овощей. Могут убивать листерии кипячение или обработка высокими температурами, воздействие ультрафиолетового облучения и специальные дезинфицирующие растворы.
Как можно заразиться листериозом?
Основными источниками инфекции для людей являются животные – дикие и домашние, которые, в свою очередь, заражаются листериозом, употребляя инфицированную воду из водоемов, едят зараженные корма с микробами, проглатывают частицы земли и пыли с листериями. При заражении они затем выделяют микробы с любыми из биологических жидкостей – это моча, кал, слюна, кровь и т.д. За счет этого возбудители снова попадают в окружающую среду, и становятся источником инфекции для окружающих животных и человека. Могут также заражаться животные, которые поедают питательные корма – мясокостную муку из забитых больных животных.
Важно
У человека заражение происходит различными способами. Основным из них является пищевой, с инфицированными продуктами, и водный, с зараженной листериями водой. Также возможно воздушно-капельное заражение, а плод у беременных женщин инфицируется, если микробы проходят сквозь плаценту.
Будущие матери могут заражаться листериозом при наличии контактов с животными и птицами (дикие и домашние), при употреблении непастеризованного и некипяченого молока любых животных. Также возможна инфекция при поедании фруктов, овощей или ягод, которые собирались на территориях, где имеются зараженные животные, и которые также не прошли термической обработки и тщательного мытья. Опасно в плане заражения плохо обработанное мясо и рыба, а также другие продукты, если в доме обитают крысы и мыши, разводят кроликов.
Опасны такие продукты как сырая капуста, если ее поливали зараженной водой или хранили в погребе, а также сырое яйцо, мороженое, мягкие сыры, которые готовили из непастеризованного молока. Опасно вдыхание бактерий при разделке птицы или тушек животных, при контакте с людьми, которые заражены листериозом, и после которых женщина не мыла руки, употребляя пищу.
Для листериоза типичны эпизодические заболевания, но могут возникать и вспышки инфекции в отделениях гинекологии и роддомах. В них женщины, находящиеся на лечении или наблюдающиеся по беременности, могут стать источником инфекции, сами не подозревая о той опасности, которая возможна. Они выделяют возбудителей с калом, слюной и мочой очень длительный период. Заразить других женщин может беременная и роженица, а также инфицированный новорожденный ребенок, они выделяют микробов до двух недель. Основное время заболевания – это теплое время года, с конца весны до конца лета.
Листериоз — это инфекционное заболевание, вызываемое бактерией Listeria monocytogenes, и особенно опасно для беременных женщин. Многие специалисты подчеркивают, что эта болезнь, часто называемая «болезнью холодильников», может привести к серьезным последствиям для плода, включая выкидыши, преждевременные роды и инфекции новорожденных. Женщины в положении должны быть особенно осторожны с продуктами, которые могут содержать эту бактерию, такими как сыры, мясные деликатесы и непастеризованные молочные продукты. Важно тщательно мыть фрукты и овощи, а также избегать употребления сомнительных продуктов. Несмотря на то что риск относительно невелик, осведомленность и профилактика играют ключевую роль в защите здоровья как матери, так и ребенка. Мнения врачей и акушеров единодушны: соблюдение простых правил гигиены и питания может значительно снизить вероятность заражения.

Симптомы листериоза при беременности
Сочетание инфекции с беременностью – ситуация крайне опасная, так как женщина передает листерии плоду, у которого организм просто не в состоянии с ними справляться из-за слабости иммунной системы. Это вызывает тяжелые поражения организма, вплоть до внутриутробной гибели. Нередко возможна ситуация, которую в медицине называют принципом «пинг-понга», с инфицированием плода от матери, и активизацией работы его иммунной системы, которая постепенно учится справляться с возбудителем. Однако за счет организма матери он вновь получает новых возбудителей, которые потом передает обратно матери.
Обратите внимание
У обычных людей листериоз развивается далеко не всегда, так как активный иммунитет справляется с возбудителем. Но при беременности иммунная защита закономерно ослабевает, чтобы можно было выносить ребенка, и иммунная система не атаковала его клетки. Поэтому возможны и инфекции, которые поражают организм женщины и плода.
Период инкубации сильно разнится, начиная от 3-5 дней и до полутора месяцев, проявления могут быть различными, и поэтому выделено несколько клинических форм инфекции. Для беременных типично несколько из них, которые имеют свои особенности:
- Ангинозно-септическое течение листериоза – в начальной стадии практически не отличается от обычного течения гнойной ангины. Типично повышение температуры до 39°C, выражена болезненность при глотании, возникает головная боль и слабость, возможна тошнота и сонливость, недомогание. При осмотре глотки типично наличие сероватых пленок или красных ярких ямок в области отечных и воспаленных миндалин. Если не начинать лечение этой формы ангины, микробы могут быстро проникать в кровь, приводя к формированию сепсиса. Это проникновение микробов в кровь с распространением их по всем внутренним органам с образованием очагов воспаления. Лихорадка усиливается и утяжеляется, типичны резкие скачки температуры с покраснением лица, кашлем и насморком, недомоганием, резким увеличением лимфоузлов по всему телу. По поверхности кожи формируется ярко-красная сыпь, имеющая неправильную форму и при растягивании бледнеющая.
- Неврологическая форма листериоза может развиваться у тех беременных, у которых до беременности были проблемы с иммунитетом. Кроме того, она типична и для зараженных новорожденных детей. Микробы проникают через гематоэнцефалический барьер, препятствие, ограждающее головной и спинной мозг, что грозит воспалением мозговых оболочек – менингитом или образованию абсцессов, полостей в мозге, заполненных гноем. Типично повышение температуры, сильные головные боли, дрожь конечностей, боли в области суставов и позвоночника, тошнота и рвота, нарушение двигательных функций или чувствительности в конечностях, судороги, нарушение ориентации во времени и пространстве, спутанность сознания, бред.
- Нетипичные формы листериоза могут быть похожи на ОРВИ ил кишечные инфекции, в связи с чем сложно распознаются. Типично повышение температуры и похожие на грипп проявления с болью в суставах, головными болями и ломотой мышц, дискомфортом в спине и пищеварительными расстройствами. Нередко их принимают за отравления или простуды.
Важно
Важно немедленно обратиться к врачу при подозрении на листериоз, если проявления пищеварительных расстройств длятся около двух дней, а остальные симптомы могут проявиться позднее, на протяжении нескольких недель.
Чем опасен листериоз во время беременности?
Сама инфекция при беременности очень редко имеет тяжелые симптомы, наиболее часто проявления длятся как простуда около 5 дней, но особенно опасна инфекция для плода и плаценты. Микробы проникают в пространство между ворсинами плаценты, которыми она крепится к области матки, формируют воспаление в области плаценты, что приводит к тому, что на обширных участках орган перестает функционировать в полном объеме, что грозит гипоксией плода – нарушением доставки к нему кислорода. Одновременно страдает и доставка питания, это также усугубляет положение.
Заражение до 15-16-ти недель беременности приводит к гибели плода и выкидышам с кровотечением, иногда необходимо выскабливание замершего в утробе зародыша с остатками плодного яйца.
Инфицирование во второй половине беременности, периода 20-22 недель, при относительной развитости плаценты, может формироваться несколько вариантов событий, обладающих достаточно неблагоприятным прогнозом:
- гибель плода, спровоцированная инфекцией, что приводит к преждевременным родам и мертворождению. Обычно женщина перестает ощущать, что плод шевелится в утробе, обращаясь к врачу или на УЗИ, обнаруживается гибель малыша, что служит поводом для направления в стационар и родоразрешения.
- если женщина не обращается за помощью к врачам на протяжении 2-3 суток, отмирающие части погибшего плода начинают резорбироваться в кровь, что приводит к лихорадке, слабости и тошноте. Могут начинаться роды или же женщина, не ощущая шевелений, обращается в стационар, необходима стимуляция родов. Затем необходимо длительное лечение, чтобы устранить все последствия инфекции для организма матери.
Листерия активно инфицирует плаценту, плодные оболочки и воды, а также распространяется на тело плода.

Последствия листериоза для плода (ребенка)
Если при заражении листериозом дети выживают, обычно запускается процесс преждевременных родов. Малыш может родиться очень болезненным, либо инфекция начинается сразу после рождения, возникают проблемы, связанные с общим заражением крови – сепсисом. Возможны нарушения дыхания, выраженная лихорадка и поражения кожи в виде язвенных дефектов, различного рода повреждения всех внутренних органов и нервной системы в форме менингитов.
Часть детей, которые рождены от зараженных в последние недели беременности матерей, могут родиться внешне здоровыми, и первые признаки инфекции в виде менингита у них проявляются примерно через неделю или несколько недель после родов. Это поздний старт инфекции, который формируется при заражении ребенка во время родов, так как листерии могут обитать у болеющей женщины в области влагалища и шейки матки. Также возможна передача инфекции не от матери, а от третьих лиц. Зачастую дети при подобных поражениях гибнут или у них остаются необратимые изменения в органах и системах на всю оставшуюся жизнь.
Возможна генерализованная форма инфекции при рождении, она проявляется в нарушениях работы сердца и дыхательных расстройствах, что приводит к необходимости помещения крохи в реанимационное отделение. Дети обычно имеют малый вес и обильную красноту в области конечностей, спины и ягодиц, слизистых рта и конъюнктивы глаз. Нередко они погибают от полиорганной недостаточности в первые сутки жизни, особенно на фоне развития гнойного менингита и отека мозга.
Если женщина, которая была заражена листериозом, после родов резко отмечает снижение температуры ниже 36°C, и затем лихорадки больше не возникает, листериоз может переходить в хроническую форму. Без лечения такая инфекция периодически будет давать симптомы, похожие на простуду и поражения глаз в форме конъюнктивита, а затем у нее образуется невынашивание беременности, гибель плода внутриутробно и пороки развития, что ведет в итоге к бесплодию.
Анализ на листериоз у беременных: норма и расшифровка
Для подтверждения диагноза только симптомов недостаточно, они похожи на многие другие инфекции, поэтому нужно определение самой листерии в моче, крови или слюне, кале. В общем анализе крови для листериоза типично повышение уровня моноцитов, но точные результаты дает только исследование крови на выявление листерий – антитела при помощи реакций РНГА или РСК. В норме антител к листериям быть не должно, и если определяется высокий титр антител к листерии, диагноз подтверждается. Также можно определить сам возбудитель за счет применения ПЦР с определением ее ДНК, материал берется со слизистой влагалища, носоглотки, мокроты. Обычно проводят целый курс обследований, чтобы точно определить природу инфекции, степень тяжести и прогнозы.
Лечение листериоза при беременности
Важно
При заражении листериозом необходима срочная госпитализация и курс лечения только в стационаре.
Применяютсяантибиотикис учетом их влияния на беременность и развитие плода. Обычно это пенициллины или та группа, которая определена по результатам чувствительности к антибиотикам. Терапия может длиться до трех недель.
В ранние сроки беременности при заражении листериозом необходимо прерывание беременности по медицинским показаниям, при наличии инфекции во второй половине гестации при раннем лечении есть шансы того, что кроха внутриутробно не заразится инфекцией.
Помимо антибиотиков применяют иммуностимуляторы – гипериммунные глобулины, иммунофан и другие, безопасные при гестации. Параллельно с ними назначается курс профилактики грибковой инфекции и дисбактериоза, применяют препараты молочнокислой флоры и противогрибковые препараты.
При выявлении листериоза у новорожденного, его переводят в боксированное отделение реанимации, где применяют антибиотики внутривенно и противогрибковые препараты, а также средства для нормальной свертываемости крови. Показаны препараты, нормализующие мозговое кровообращение и снимающие отек мозговой ткани, препараты для поддержания работы внутренних органов, подается кислород через маску или же ребенок подключается к аппарату искусственной вентиляции легких.
Методы профилактики листериоза при гестации
Есть ряд рекомендаций, которые могут существенно снизить риск заражения листериозом при беременности. К ним относятся довольно простые, но действенные методы:
- нужно тщательное приготовление рыбы, птицы или мяса, важно прожаривать или отваривать их до полной готовности, без сока и крови в середине. Рыбу нужно готовить особенно тщательно, запрещено есть полусырые и сырые продукты. Запрещено пробовать недоготовленные блюда во время их приготовления, в том числе сырой фарш.
- важно тщательно прогревать всю пищу из холодильника. Листерии могут заражать уже готовые блюда, тщательно обработанные до этого, и выживают и размножаются в условиях холодильника. Важно полностью разогревать все блюда, которые хранились с вечера, важно, чтобы пища полностью прогрелась. При использовании микроволновой печи для разогрева еду накрывают специальной крышкой, после разогрева нужно дать пище постоять несколько минут, чтобы разогрев был полностью завершен.
- стоит избегать полуфабрикатов, магазинной еды и блюд из кулинарии. Стоит максимально ограничивать применение колбас и разных мясных деликатесов, паштета или отварного холодного мяса, важно ограничивать употребление соленостей и копченостей из мяса, птицы, рыбы или овощей, если они не обрабатываются термически. Консервы и продукты с длительным сроком хранения, которые не нужно хранить в холодильнике, после вскрытия употребляются на протяжении двух часов.
- стоит избегать салатов и различных блюд готового производства из магазинов и ресторанов, особенно если в них есть курица, яйцо или морепродукты. Стоит отказаться на время беременности от шашлыка.
- важно избегать приема некипяченого и непастеризованного молока – коровьего и козьего, а также продуктов, которые из него готовятся. Не стоит есть мягкие сыры, а также те, что с плесенью. Важно изучать этикетки, чтобы на них было указание, что продукт изготовлен из пастеризованного молока.
- все фрукты и овощи нужно тщательно мыть под горячей водой, стоит очищать их от кожуры перед едой.
- все тряпки, губки для мытья посуды и кухонные полотенца обрабатываются дезрастворами или кипятятся, часто заменяются новыми. В сырых тряпках активно размножаются микробы, поэтому они должны регулярно стираться и обрабатываться. Можно также пользоваться одноразовыми бумажными изделиями.
- нельзя хранить долго приготовленную пищу, в идеале нужно готовить на один прием пищи, чтобы не было риска развития микробов в продуктах и заражения ими организма. Все блюда с короткими сроками годности нужно есть сразу, не храня их в холодильнике.
- нужен строгий контроль за температурой в холодильнике и морозилке, важно регулярно мыть, просушивать и проветривать холодильник, обрабатывать его дезрастворами.
Важно помнить о том, что листерии очень выносливы к негативным влияниям внешней среды, они выживают при низких температурах. Поэтому стоит прогревать все блюда, которые допускают это, после хранения в холодильнике.
Парецкая Алена, педиатр, медицинский обозреватель
Вопрос-ответ
Чем опасен листериоз при беременности?
Беременные женщины болеют листериозом в ~10–100 раз чаще, чем население в целом. Листериоз у беременной протекает в легкой форме, но может привести к гибели плода или новорожденного. Чаще всего от листериоза погибают недоношенные новорожденные с низкой массой тела и баллом по шкале Апгар <, 5 на пятой минуте жизни.
Каков риск заражения листериозом во время беременности?
Ежегодно в Соединенных Штатах примерно 1 из 25 000 беременных женщин заражается листерией. Листерия может передаваться вашему ребенку во время беременности и причинять вред , даже если вы не чувствуете себя очень плохо.
Чем опасна листерия?
Патогенез и симптоматика листериоза Проникающие в организм листерии провоцируют лихорадочную реакцию. Чаще всего они оседают в лифоузлах, миндалинах и в других органах. Могут провоцировать образование в них некротических очагов. При тяжелом течении листериоза развивается сепсис.
Где можно заразиться листериозом?
По сообщениям врачей, чаще всего люди инфицируются алиментарным путем через зараженные овощи, собранные с участков, где использовали для полива необеззараженные сточные воды и навоз. Факторами передачи могут стать некипяченое молоко, сыры и другие молочные продукты, загрязненная вода.
Советы
СОВЕТ №1
Избегайте употребления непастеризованных молочных продуктов. Пастеризация убивает бактерии, включая Listeria, поэтому выбирайте только пастеризованные молоко и сыры, чтобы снизить риск заражения.
СОВЕТ №2
Тщательно мойте фрукты и овощи перед употреблением. Даже если они выглядят чистыми, на их поверхности могут находиться бактерии. Используйте чистую воду и щетку для мытья, чтобы удалить возможные загрязнения.
СОВЕТ №3
Обратите внимание на срок годности и условия хранения продуктов. Листерия может размножаться при низких температурах, поэтому следите за тем, чтобы продукты хранились в холодильнике не дольше рекомендованного срока.
СОВЕТ №4
Избегайте употребления готовых мясных продуктов, таких как деликатесы и консервы, без предварительной термической обработки. Если вы хотите их съесть, обязательно прогрейте до температуры не менее 74°C, чтобы убить возможные бактерии.